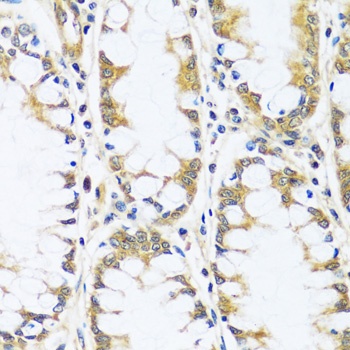
BLOC1S3 Antibody

You have no items in your shopping cart.
All Products
- TNFRSF10A Antibody [orb1239340]Featured

ELISA, ICC, IF, IHC-P, WB
Human, Mouse, Rat
Rabbit
Polyclonal
Unconjugated
0.1 mg, 0.02 mg - CDKN2A Antibody [orb1239282]Featured

ELISA, IF, IHC-P, WB
Human, Mouse, Rat
Rabbit
Polyclonal
Unconjugated
0.1 mg, 0.02 mg - ERN1 Antibody [orb1239523]Featured

ELISA, ICC, IF, IHC-P, WB
Human, Mouse, Rat
Rabbit
Polyclonal
Unconjugated
0.02 mg, 0.1 mg - IRF7 Antibody [orb1239524]
ELISA, IHC-P, WB
Human, Mouse, Rat
Rabbit
Polyclonal
Unconjugated
0.02 mg, 0.1 mg - SARS-CoV-2 (COVID-19) Spike RBD Antibody [orb1239994]
ELISA, IF, IHC, WB
Virus
Rabbit
Polyclonal
Unconjugated
0.02 mg, 0.1 mg - ADAM17 Antibody [orb1240074]Featured

ELISA, ICC, IF, WB
Human, Rat
Mouse
Rabbit
Polyclonal
Unconjugated
0.1 mg, 0.02 mg - HNRNPA1 Antibody [orb1256354]Featured

IF, IHC, WB
Human, Mouse, Rat
Rabbit
Polyclonal
Unconjugated
100 μl